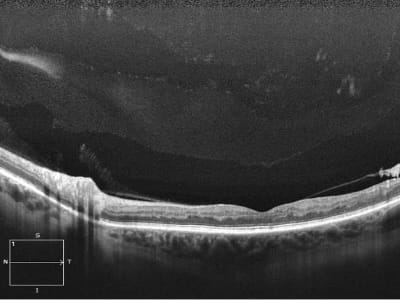
Cirrus HD-OCT Premium

Equipment検査設備
八王子友愛眼科で導入している検査設備のご紹介
超広角走査型レーザー検眼鏡 (Optos社 California)


Californiaは、画角200度・眼底の80%以上の領域を、無散瞳・非接触で撮影ができます。
画像は合成カラーで実際の色調とは異なりますが、眼底周辺部の病変も見逃さずに捉えることが可能です。具体的には網膜剥離・糖尿病網膜症などの網膜疾患・黄斑部疾患、動脈硬化や高血圧などの全身疾患、小児の撮影に優れた機能を持ち、様々な撮影が可能です。
自発蛍光
網膜色素上皮(RPE)にあるリポフスチン(加齢に伴い蓄積する老化色素)が発する蛍光に、緑色のレーザー光を当てることで、造影剤を使用することなく蛍光強度を調べ、RPE機能を視覚化して評価することができます。
加齢黄斑変性症、網膜色素変性症、中心性漿液性網脈絡膜症、増殖性糖尿病網膜症などで自発蛍光画像が有用となります。

造影剤検査
フルオレセインという造影剤(色素)を用いて網膜血管の異常を捉えることで、様々な病変の診断や、レーザー治療、手術など今後の治療方針を診断することが可能です。さらに当院のカメラでは、インドシアニングリーンという色素と波長の違うフィルターを使用するもう一つの造影剤検査も可能で、FAGでは検出困難な網膜下に存在する脈絡膜病変の評価も同時に行うことができます。


網膜静脈分枝閉塞症
VX-10
眼底所見を詳細に記録するには広角眼底カメラだけでは不十分であり、別のタイプのカメラも必要になります。VX-10で取得した画像は直接眼で見た色調と同じであり、加齢黄斑変性症や糖尿病網膜症などの詳細な黄斑部の状態や、緑内障では視神経乳頭の形状や神経線維の走行など後極部の微細な記録が行えます。

加齢黄斑変性症

検査イメージ
Cirrus HD-OCT Premium
網膜の断層写真や血管状態を記録する、OCTという検査機器です。
OCTとは、Optical Coherence Tomography(光干渉断層撮影)の略語で、光の干渉性を利用することで網膜の断層像を描写する機器です。
非接触・非侵襲の撮影が行え、被爆等の心配もなく安心して断層像の取得が可能です。
当院ではカールツァイス社の機器を導入しています。
この機器は撮影速度が早く、患者様の負担を軽減するとともに、高解像度かつ広範囲(最大長:12mm)の撮影が行えますので僅かな疾患でも捉えることができます。
緑内障や糖尿病網膜症、加齢黄斑変性症など、多種多様な眼底疾患の診断や経過観察に有用となります。

OCT Angiography(OCTA)
また、この機種にはOCT Angiography(OCTA)という機能も備わっており、網膜血管の形状を高解像度で撮影することも可能です。
眼底の血管病変を調べるには、点滴から造影剤を静注する蛍光眼底造影検査という検査を行う必要があったために、アレルギー等の心配も懸念されました。OCTAを用いることで、造影剤を使わず安全に網膜の血管構造の取得が可能になりました。
糖尿病網膜症や網膜血管閉塞症、加齢黄斑変性症などの血管病変に対し、リスクを抑えながら頻回の検査を行うことができます。(蛍光眼底造影検査でのみ得られる所見もあります)

網膜静脈分枝閉塞症

糖尿病網膜症
DRI OCT Triton(TOPCON)
DRI OCT TritonはSwept Source光源を採用しています。1秒未満の撮影時間で網膜から脈絡膜・強膜まで、高精かつ鮮明に描写することが可能です。
白内障や硝子体混濁による影響も受けにくいため、そのような疾患を有する場合でも網膜断層写真を撮影することができます。 さらにOCT Angio(造影剤を使わない血管撮影)・眼底写真・自発蛍光・蛍光眼底造影剤検査も可能です。
血管走行、眼底の色調、乳頭形状・血管走行などを明瞭な画像で観察することが出来ます。

CASIA2


前眼部疾患を診断するための検査機器であり、非接触で患者様への負担をかけずに、眼の表面(角膜)から内面(水晶体)までの3次元撮影が可能です。
角膜形状解析
角膜混濁などにおける病変の深達度の把握、円錐角膜などにおける不正乱視の測定、角膜移植後の移植片の状態の観察を行う解析です。
白内障術前後の検査
白内障手術に用いる眼内レンズの乱視適応判断や、手術による角膜形状変化を測定できます。
また術前の水晶体の状態確認や、術後の眼内レンズの位置確認も可能です。
隅角詳細検査
緑内障の診断に有用な隅角形状(眼内の水の流出路)を360°観察でき、隅角角度の数値での評価も行えます。
ARGOS(アルゴス)
白内障手術に必要な眼軸長の測定をする検査機器です。レンズの度数を算出する計算式も豊富に組み込まれており、それぞれの患者様に最適なレンズを選択できます。
1度の測定で6回撮影が可能になり、従来より精度の高い眼軸長の測定と正確なデータの算出が可能になりました。

特徴1
測定中に2次元画像をリアルタイムで表示でき、視能訓練士がその場でセルフチェックできます。

※眼軸長と角膜の状態を視能訓練士が確認しながら、測定します。
特徴2
眼の表面(角膜頂点)から奥(網膜)までの4つの組織のそれぞれの異なる屈折率を用いて、眼軸長を測定します。どの組織も同じ屈折率を用いて測定していた従来のものに比べて、より正確なデータの算出が可能です。

特徴3
レンズの度数を算出する計算式も豊富に組み込まれており、患者様に最適なレンズを選択できます。

※手術計画書
超音波Aモード
TOMEY UD-8000
TOMEY UD-8000は超音波を出すプローブを目に接触させ、眼球の内径を計測することで眼内レンズ度数を算出するための機器です。超音波を使用することで、重度白内障の症例でも測定が可能になります。直接目に触れる接触型検査ですが、麻酔の目薬をするので痛みはありません。
測定精度が高いArgosと、測定不能眼がほぼ無い超音波Aモードを組み合わせて検査を行いますので、より信頼性の高い検査環境になっています。


ヘススクリーン
眼球の動きを詳細に調べ、定量化するための検査です。
赤緑の眼鏡を装用し暗室にて検査を行います。
眼を動かすための神経などに何らかの異常が生じると、外眼筋が正常に動かなくなり斜視が生じます。
どの筋肉に異常があるのかを確認し、斜視の原因を調べ、経過観察を行います。

Synoptphore 大型弱視鏡
弱視や斜視の検査や訓練に用いる検査です。
両眼視機能(左右眼で見た映像を脳内で1つに重ねて知覚する感覚機能)評価や、斜視の分類や角度の定量評価を行います。小児でも詳しい検査が行うことができます。(乳児など低年齢では不可)

HFA(ハンフリーフィールドアナライザー)


緑内障の早期発見や経過観察、視野欠損を伴う疾患に有用な視野検査機器です。主に中心付近(30°以内)の視野を測定します。
暗室で行う検査で、片眼ずつ5分程度かかります。検査方法は片眼をガーゼで隠し、器械に顔を乗せて中を見ます。正面の固視灯を見て眼を動かさないようにします。ドームの中で明るさの異なる光が見えたらボタンを押すということを繰り返します。
光の点滅により網膜の感度を各領域別に評価します。当院ではGPA(緑内障視野進行解析)というプログラムを用いて結果の解析を行っております。これは設定したベースライン視野から一定の変動幅以上の変化があった場合、測定点毎に視野進行確率プロットで表示され、測定結果が進行か否かを統計学的に解析し判断するもので、定期的に視野検査を行うことで緑内障の進行スピードや将来の進行状態を予測することができます。これにより各個人にあった治療法を選択しております。
ゴールドマン視野計

ゴールドマン視野計は、ドーム内を動く光が出るので「動的視野検査」といいます。
主に視野の中心30°内を検査する静的自動視野計と比べて、広い範囲(周辺視野)を調べることができます。
光視標の大きさと明るさを変えることで、網膜の感度の分布も同時に調べることができます。

正常視野 右眼

緑内障視野 右眼
自動視野計はコンピュータが自動で測定しますが、ゴールドマン視野計は検査員(視能訓練士)が患者様の反応をみながら手動で検査を進めます。
患者様一人一人に合わせてペースを調整するので、自動視野計での検査が難しい方でも検査ができます。
アイケアic100(M.E.Technica)
手持ちタイプの眼圧計です。直径1.7㎜のプローブを器械に装填し、数秒で測定できます。車椅子の方や小さなお子様、瞼裂が狭くて空気が出るタイプの眼圧計では測定が困難な方などに適しており、場所を選ばず測定することが可能です。
麻酔薬は不要で、眼に接触するプローブもディスポーザブルの為、衛生的です。


※検査イメージ
トノレフⅢ(ニデック社)
遠視・近視・乱視の屈折度の測定、角膜の形状、眼圧を測定します。
空気が出るタイプの眼圧計では角膜の厚みの影響を受けますが、トノレフⅢでは角膜厚に応じた眼圧補正値も知ることができます。また、自動吐出制御機能により吐出圧が低減されるため、空気の当たり方が柔らかくなっています。1台で眼の屈折度、角膜の形状、眼圧を測定できるので、移動が少なく済みます。


スペースセイビングチャート SSC-350、SSC-370(ニデック社)
視力検査の器械です。検査距離は90㎝ですが、一般的な測定距離(5m)と同等の遠見視力測定が可能です。
内蔵の光学系により、視標窓の奥に視標が呈示される為、照度など周囲の環境の影響を受けにくく、視標の輝度を一定に保ちやすい構造になっています。
(5mの視力表もあるので、小さなお子様などスペースセイビングチャートでは検査が困難な場合はそちらで検査を行えます)

※視力検査イメージ
コントラストグレアテスター(CGT‐2000)
様々な大きさの「もの」の濃淡がどの程度までわかるかを検査する機器です。(コントラスト感度検査)
CGT‐2000は検査距離(30㎝、60㎝、1m、5m)や検査環境の明るさ(明所、薄暮、暗所、任意)の条件を選択でき、より日常生活に近い、視力検査では捉えることの出来ない微細な視機能変化を測定することができます。
また、通常のコントラスト感度検査に加え、眩しい状態(グレア状況下)でのコントラスト感度検査も行えるため、眩しさによる見えにくさの程度を調べることもできます。ただし、微細な視機能の差の定量化を目的としているため、比較的視力良好な方が検査の対象となります。
一般的に、白内障など眼球内の光の通り道に濁りがあると、コントラスト感度が低下すると言われています。視力が良好でも「なんとなく見えづらい、すっきりしない」という方は、白内障などの疾患によりコントラスト感度が低下している可能性があります。
そのため当院では、主に白内障手術適応や術前後の視機能の評価に用いています。

角膜内皮細胞撮影装置(コーナンスペキュラーマイクロスコープ ノンコンロボⅡ)
角膜内皮細胞を撮影し、その密度(数)や形態を測定する機器です。(角膜内皮細胞検査)
ノンコンロボⅡは非接触で角膜内皮細胞を撮影し、周辺部や角膜の厚みも測定可能です。患者様の負担が少なく行える検査になります。
角膜内皮細胞とは、いわゆる黒目にあたる角膜の一番内側にある六角形の細胞で、角膜の代謝や透明性の維持に重要な機能を持っていますが、再生能力がなく一度減少すると増えることはありません。そのため、角膜内皮細胞が障害されると減少の程度によっては角膜が白く濁ってしまいます。(水疱性角膜症)
加齢や手術、コンタクトレンズの不適切な使用等により角膜内皮細胞が減少する可能性があり、当院では主に白内障手術前後、ICL手術前の評価に用いています。


MR-6000
眼の屈折度数の測定、眼圧、角膜の形状解析に加え、ドライアイのスクリーニング評価をこの1台で行うことができます。
ドライアイ検査は赤外線カメラでのマイボーム腺の観察や涙液の安定性の評価などを簡便に行うことができ、ドライアイ治療の経過観察が可能です。
またQuick Refモードも搭載されており、小児や眼振で視線が安定しない方でも、素早く屈折度数を測定することができます。

ドライアイ(BUT)の検査結果

マイボーム腺を観察した結果

涙の高さの検査結果











